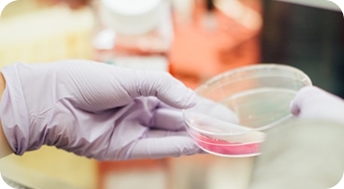

-
총무과
- 예산·계약·지출에 관한 사항 및 청사·전기·통신 시설 유지
- 원내 인사 및 민원 접수, 세입·세출 예산의 결산
-
농산물원종장
- 씨감자, 콩, 맥주보리, 마늘, 잡곡 종자 생산 공급
- 우량종자 생산을 위한 기반 조성 및 효율적 공급체계 구축
-
농업디지털센터
- 농업 공공데이터의 과학적 분석으로 농업정책 수립 기초 자료 제공
- 데이터에 근거한 자율적 의사결정을 위한 농업정보 제공
-
연구개발국
미래농업육성과
- 농업 과학기술 개발 시험 연구사업 종합 기획·조정·평가
- 제주농특산물 부가가치 향상 소재 발굴 및 제품 개발
- 데이터 기반 스마트농업 기술 개발 및 농업현장 적용
친환경연구과
- 기후변화 대응 병해충 종합관리 및 농작물 친환경 재배모델 연구
- 농경지 토양환경 및 작물양분 종합관리 기술 개발 연구
과수연구과
- 감귤 품종 육성 및 품질 향상 연구
- 아열대과수 새 소득 품목 선발 및 재배기술 개발 연구
원예작물과
- 채소류 품종 육성·보급, 품질향상 및 실용기술 개발 연구
- 식량·특용작물, 잡곡 등 품종선발 및 재배기술에 관한 연구
-
기술지원국
기술지원조정과
- 미래농업 대응 탄소중립 및 스마트농업 등 품질향상 기술보급
- 노동력 부족 해소 및 병해충 방제 등 현장중심 농업기술 개발 보급
- 제주형 치유농업 육성 및 농촌융복합 산업 활성화
농업기술센터
- 중점 기능
농업기순센터 중점 기능 표 명칭 특성화 기능 담당지역 제주농업기술센터(애월읍 상귀) 도시 근교농업 중점(키위, 채소, 도시농업) 제주시 동(洞)지역, 애월읍, 조천읍, 추자면 서귀포농업기술센터 (남원읍 하례2) 과수·아열대 농업 중점 (감귤, 아열대과수) 서귀포시 동(洞)지역, 남원읍 동부농업기술센터 (구좌읍 세화) 밭작물 중점 (당근, 무, 더덕, 콩 등) 제주시 구좌읍, 우도면, 서귀포시 성산읍, 표선면 서부농업기술센터 (한림읍 금능) 원예작물 중점 (마늘, 양파, 양배추 등) 제주시 한림읍, 한경면, 서귀포시 대정읍, 안덕면 공통업무 농업인 상담 및 교육, 농기계 임대 및 수리, 미생물 공급, 작물별 재배기술 보급 등